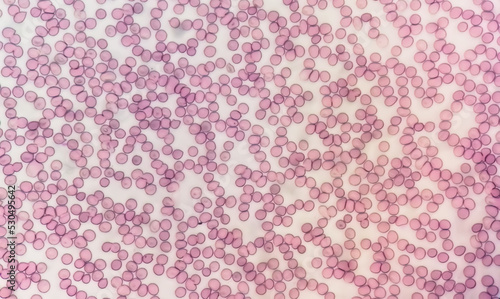
Microscopic view of hematological stained slide. thrombocytopenia. Extremely low level of platelet count in blood.

More from this collection

"bright And Bold Tropical Flowers Scattered Evenly In A Seamless Floral Pattern – Ideal For Summer Fashion Prints."

A Seamless Allover Floral Pattern Featuring Delicate Blossoms, Leaves, And Vines In A Harmonious Arrangement. Perfect For Fabric Prints, Wallpapers, Stationery, Packaging, And Branding Projects

Top And Kurti Design Floral Pattern

A Seamless Allover Floral Pattern Featuring Delicate Blossoms, Leaves, And Vines In A Harmonious Arrangement. Perfect For Fabric Prints, Wallpapers, Stationery, Packaging, And Branding Projects. The D

A Seamless Allover Floral Pattern Featuring Delicate Blossoms, Leaves, And Vines In A Harmonious Arrangement. Perfect For Fabric Prints, Wallpapers, Stationery, Packaging, And Branding Projects
View All from Collection
Explore more designs
Similar Wallpaper designs
Microscopic View Of Hematological Stained Slide. Thrombocytopenia. Extremely Low Level Of Platelet Count In Blood.

New Year's Wrapping Paper. Decorative Christmas Pattern. Pink Background. Vector Image

Brown, Building Stone, Texture, Old Wall Design, Material Marble, Background Gray Granite,

